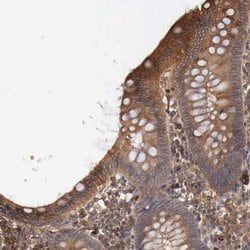
Img

PIPA551384
ARHGAP12 Polyclonal Antibody, Invitrogen™
Manufacturer: Thermo Scientific
Select a Size
| Pack Size | SKU | Availability | Price |
|---|---|---|---|
| Each of 1 | PIPA551384-Each-of-1 | In Stock | ₹ 51,397.50 |
PIPA551384 - Each of 1
In Stock
Quantity
1
Base Price: ₹ 51,397.50
GST (18%): ₹ 9,251.55
Total Price: ₹ 60,649.05
Antigen
ARHGAP12
Classification
Polyclonal
Conjugate
Unconjugated
Gene
ARHGAP12
Gene Alias
2810011M08Rik; ARHGAP12; FLJ10971; FLJ20737; FLJ21785; Rho GTPase activating protein 12; rho GTPase-activating protein 12; Rho-type GTPase-activating protein 12
Host Species
Rabbit
Purification Method
Antigen affinity chromatography
Regulatory Status
RUO
Gene ID (Entrez)
307016, 75415, 94134
Content And Storage
Store at 4°C short term. For long term storage, store at -20°C, avoiding freeze/thaw cycles.
Form
Liquid
Applications
Immunohistochemistry, Western Blot
Concentration
0.4 mg/mL
Formulation
PBS with 40% glycerol and 0.02% sodium azide; pH 7.2
Gene Accession No.
Q8C0D4, Q8IWW6
Gene Symbols
ARHGAP12
Immunogen
Recombinant protein corresponding to Human ARHGAP12
Quantity
100 μL
Primary or Secondary
Primary
Target Species
Human, Mouse, Rat
Product Type
Antibody
Isotype
IgG
Description
- Immunogen sequence: RGTQERTWKP PRWTRDASIS KGDFQNPGDQ ELLSSEENYY STSYSQSDSQ CGSPPRGWSE ELDERGHTLY TSDYTNEKWL KHVDDQGRQY YYSADGSRSE WELPKYNASS QQQREIIKSR SLDRRLQEPI VLTKWRHSTI VLDTNDKESP TASKPCFPEN ESSPSSP Highest antigen sequence identity to the following orthologs: Mouse - 86%, Rat - 86%
- GTPase activator for the Rho-type GTPases by converting them to an inactive GDP-bound state.
Compare Similar Items
Show Difference
Antigen: ARHGAP12
Classification: Polyclonal
Conjugate: Unconjugated
Gene: ARHGAP12
Gene Alias: 2810011M08Rik; ARHGAP12; FLJ10971; FLJ20737; FLJ21785; Rho GTPase activating protein 12; rho GTPase-activating protein 12; Rho-type GTPase-activating protein 12
Host Species: Rabbit
Purification Method: Antigen affinity chromatography
Regulatory Status: RUO
Gene ID (Entrez): 307016, 75415, 94134
Content And Storage: Store at 4°C short term. For long term storage, store at -20°C, avoiding freeze/thaw cycles.
Form: Liquid
Applications: Immunohistochemistry, Western Blot
Concentration: 0.4 mg/mL
Formulation: PBS with 40% glycerol and 0.02% sodium azide; pH 7.2
Gene Accession No.: Q8C0D4, Q8IWW6
Gene Symbols: ARHGAP12
Immunogen: Recombinant protein corresponding to Human ARHGAP12
Quantity: 100 μL
Primary or Secondary: Primary
Target Species: Human, Mouse, Rat
Product Type: Antibody
Isotype: IgG
Antigen:
ARHGAP12
Classification:
Polyclonal
Conjugate:
Unconjugated
Gene:
ARHGAP12
Gene Alias:
2810011M08Rik; ARHGAP12; FLJ10971; FLJ20737; FLJ21785; Rho GTPase activating protein 12; rho GTPase-activating protein 12; Rho-type GTPase-activating protein 12
Host Species:
Rabbit
Purification Method:
Antigen affinity chromatography
Regulatory Status:
RUO
Gene ID (Entrez):
307016, 75415, 94134
Content And Storage:
Store at 4°C short term. For long term storage, store at -20°C, avoiding freeze/thaw cycles.
Form:
Liquid
Applications:
Immunohistochemistry, Western Blot
Concentration:
0.4 mg/mL
Formulation:
PBS with 40% glycerol and 0.02% sodium azide; pH 7.2
Gene Accession No.:
Q8C0D4, Q8IWW6
Gene Symbols:
ARHGAP12
Immunogen:
Recombinant protein corresponding to Human ARHGAP12
Quantity:
100 μL
Primary or Secondary:
Primary
Target Species:
Human, Mouse, Rat
Product Type:
Antibody
Isotype:
IgG
Antigen: CSTF2
Classification: Polyclonal
Conjugate: Unconjugated
Gene: CSTF2
Gene Alias: alphaCstF-64 variant 4; betaCstF-64 variant 1; betaCstF-64 variant 2; betaCstF-64 variant 3; C630034J23Rik; CF-1 64 kDa subunit; cleavage stimulation factor 64 kDa subunit; Cleavage stimulation factor subunit 2; cleavage stimulation factor, 3' pre-RNA subunit 2; cleavage stimulation factor, 3' pre-RNA subunit 2, 64 kDa; cleavage stimulation factor, 3' pre-RNA, subunit 2; cleavage stimulation factor, 3' pre-RNA, subunit 2, 64kD; cleavage stimulation factor, 3' pre-RNA, subunit 2, 64kDa; CstF 64; CSTF 64 kDa subunit; Cstf2; Cstf64; CstF-64; mir-3112
Host Species: Rabbit
Purification Method: Antigen affinity chromatography
Regulatory Status: RUO
Gene ID (Entrez): 108062, 1478, 683927
Content And Storage: Store at 4°C short term. For long term storage, store at -20°C, avoiding freeze/thaw cycles.
Form: Liquid
Applications: Immunocytochemistry, Immunohistochemistry, Western Blot
Concentration: 0.2 mg/mL
Formulation: PBS with 40% glycerol and 0.02% sodium azide; pH 7.2
Gene Accession No.: P33240, Q8BIQ5
Gene Symbols: CSTF2
Immunogen: Recombinant protein corresponding to Human CSTF2
Quantity: 100 μL
Primary or Secondary: Primary
Target Species: Human, Mouse, Rat
Product Type: Antibody
Isotype: IgG
Antigen:
CSTF2
Classification:
Polyclonal
Conjugate:
Unconjugated
Gene:
CSTF2
Gene Alias:
alphaCstF-64 variant 4; betaCstF-64 variant 1; betaCstF-64 variant 2; betaCstF-64 variant 3; C630034J23Rik; CF-1 64 kDa subunit; cleavage stimulation factor 64 kDa subunit; Cleavage stimulation factor subunit 2; cleavage stimulation factor, 3' pre-RNA subunit 2; cleavage stimulation factor, 3' pre-RNA subunit 2, 64 kDa; cleavage stimulation factor, 3' pre-RNA, subunit 2; cleavage stimulation factor, 3' pre-RNA, subunit 2, 64kD; cleavage stimulation factor, 3' pre-RNA, subunit 2, 64kDa; CstF 64; CSTF 64 kDa subunit; Cstf2; Cstf64; CstF-64; mir-3112
Host Species:
Rabbit
Purification Method:
Antigen affinity chromatography
Regulatory Status:
RUO
Gene ID (Entrez):
108062, 1478, 683927
Content And Storage:
Store at 4°C short term. For long term storage, store at -20°C, avoiding freeze/thaw cycles.
Form:
Liquid
Applications:
Immunocytochemistry, Immunohistochemistry, Western Blot
Concentration:
0.2 mg/mL
Formulation:
PBS with 40% glycerol and 0.02% sodium azide; pH 7.2
Gene Accession No.:
P33240, Q8BIQ5
Gene Symbols:
CSTF2
Immunogen:
Recombinant protein corresponding to Human CSTF2
Quantity:
100 μL
Primary or Secondary:
Primary
Target Species:
Human, Mouse, Rat
Product Type:
Antibody
Isotype:
IgG
Antigen: RENBP
Classification: Polyclonal
Conjugate: Unconjugated
Gene: RENBP
Gene Alias: AGE; GlcNAc 2-epimerase; N-acetyl-D-glucosamine 2-epimerase; N-acylglucosamine 2-epimerase; RBP; RENBP; renin binding protein; renin-binding protein; RnBP
Host Species: Rabbit
Purification Method: Antigen affinity chromatography
Regulatory Status: RUO
Gene ID (Entrez): 19703, 5973, 81759
Content And Storage: Store at 4°C short term. For long term storage, store at -20°C, avoiding freeze/thaw cycles.
Form: Liquid
Applications: Immunohistochemistry, Western Blot
Concentration: 0.05 mg/mL
Formulation: PBS with 40% glycerol and 0.02% sodium azide; pH 7.2
Gene Accession No.: P51606, P51607, P82343
Gene Symbols: RENBP
Immunogen: Recombinant protein corresponding to Human RENBP
Quantity: 100 μL
Primary or Secondary: Primary
Target Species: Human, Mouse, Rat
Product Type: Antibody
Isotype: IgG
Antigen:
RENBP
Classification:
Polyclonal
Conjugate:
Unconjugated
Gene:
RENBP
Gene Alias:
AGE; GlcNAc 2-epimerase; N-acetyl-D-glucosamine 2-epimerase; N-acylglucosamine 2-epimerase; RBP; RENBP; renin binding protein; renin-binding protein; RnBP
Host Species:
Rabbit
Purification Method:
Antigen affinity chromatography
Regulatory Status:
RUO
Gene ID (Entrez):
19703, 5973, 81759
Content And Storage:
Store at 4°C short term. For long term storage, store at -20°C, avoiding freeze/thaw cycles.
Form:
Liquid
Applications:
Immunohistochemistry, Western Blot
Concentration:
0.05 mg/mL
Formulation:
PBS with 40% glycerol and 0.02% sodium azide; pH 7.2
Gene Accession No.:
P51606, P51607, P82343
Gene Symbols:
RENBP
Immunogen:
Recombinant protein corresponding to Human RENBP
Quantity:
100 μL
Primary or Secondary:
Primary
Target Species:
Human, Mouse, Rat
Product Type:
Antibody
Isotype:
IgG
Antigen: ARMCX4
Classification: Polyclonal
Conjugate: Unconjugated
Gene: ARMCX4
Gene Alias: armadillo repeat containing, X-linked 4; armadillo repeat containing, X-linked 4 pseudogene; armadillo repeat-containing X-linked protein 4; ARMCX4; CXorf35; GASP4
Host Species: Rabbit
Purification Method: Antigen affinity chromatography
Regulatory Status: RUO
Gene ID (Entrez): 100131755
Content And Storage: Store at 4°C short term. For long term storage, store at -20°C, avoiding freeze/thaw cycles.
Form: Liquid
Applications: Immunohistochemistry
Concentration: 0.05 mg/mL
Formulation: PBS with 40% glycerol and 0.02% sodium azide; pH 7.2
Gene Accession No.: Q5H9R4
Gene Symbols: ARMCX4
Immunogen: Recombinant protein corresponding to Human ARMCX4
Quantity: 100 μL
Primary or Secondary: Primary
Target Species: Human
Product Type: Antibody
Isotype: IgG
Antigen:
ARMCX4
Classification:
Polyclonal
Conjugate:
Unconjugated
Gene:
ARMCX4
Gene Alias:
armadillo repeat containing, X-linked 4; armadillo repeat containing, X-linked 4 pseudogene; armadillo repeat-containing X-linked protein 4; ARMCX4; CXorf35; GASP4
Host Species:
Rabbit
Purification Method:
Antigen affinity chromatography
Regulatory Status:
RUO
Gene ID (Entrez):
100131755
Content And Storage:
Store at 4°C short term. For long term storage, store at -20°C, avoiding freeze/thaw cycles.
Form:
Liquid
Applications:
Immunohistochemistry
Concentration:
0.05 mg/mL
Formulation:
PBS with 40% glycerol and 0.02% sodium azide; pH 7.2
Gene Accession No.:
Q5H9R4
Gene Symbols:
ARMCX4
Immunogen:
Recombinant protein corresponding to Human ARMCX4
Quantity:
100 μL
Primary or Secondary:
Primary
Target Species:
Human
Product Type:
Antibody
Isotype:
IgG